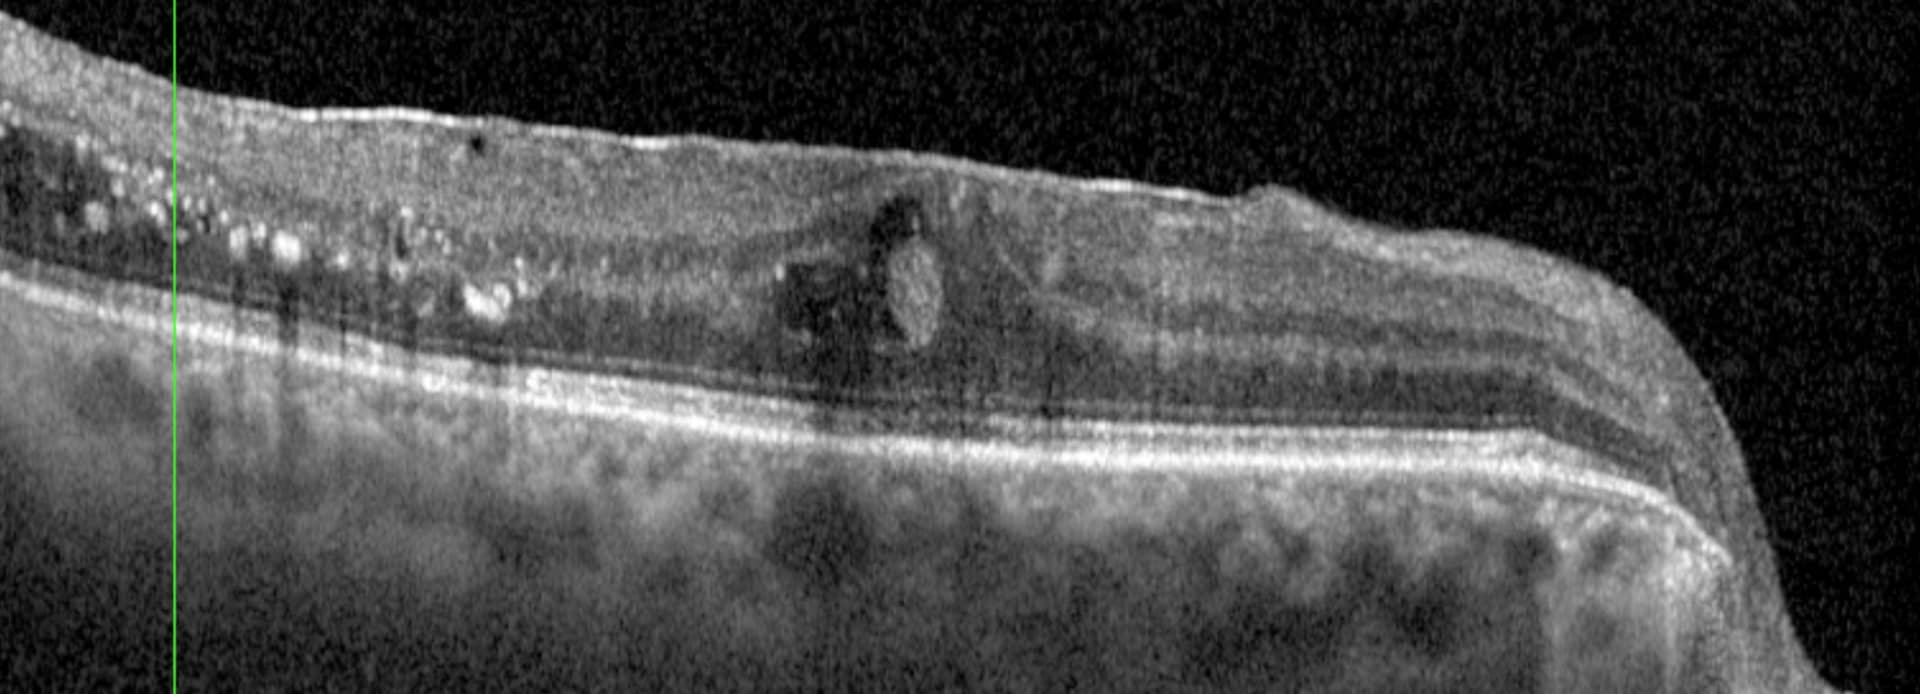

Diabète

Le diabète est une maladie systémique fréquente avec une prévalence augmentant au niveau mondial. Cette pathologie peut affecter l’œil de nombreuses façons parmi les plus fréquentes la rétinopathie diabétique et la maculopathie diabétique, responsables de baisse d’acuité visuelle.
Pourquoi le diabète atteint-il les yeux ?
L’hyperglycémie chronique, c’est-à-dire le taux de sucre dans le sang élevé, entraine une atteinte des petits vaisseaux dans tout le corps. Comme la rétine est le siège d’une importante circulation microvasculaire, elle est souvent le siège des premières atteinte du diabète (tout comme les reins).
Je suis diabétique, suis-je à risque ?
Les diabétiques de type 1 sont touchés plus précocement en raison de variations plus intenses de la glycémie (car la production d’insuline est atteinte par la maladie) et plus sévèrement que les diabétiques de type 2 qui se caractérise par une résistance à l’insuline (désensibilisation des cellules) et qui s’accompagne souvent d’autres facteurs de risque cardio-vasculaires (hypertension artérielle, hypercholestérolémie, etc.).
Quelles sont les atteintes oculaires possibles ?
Comme indiqué ci-dessus, les vaisseaux rétiniens sont d’abord touchés induisant une rupture de la membrane hémato-rétinienne ce qui induit des hémorragies, l’accumulation de lipoprotéines appelés « exsudats », et de déchets cellulaires appelés « nodules cotonneux », le développement de micro-anévrismes et le relâchement de molécules pour développer de nouveaux vaisseaux. Ces signes caractérisent la rétinopathie diabétique. Parallèlement, le centre de la rétine, appelé la macula, est touché par les mêmes phénomènes avec souvent l’accumulation de liquide intra-rétinien que l’on désigne sous le terme œdème maculaire diabétique ou maculopathie diabétique. Lorsque l’atteinte s’aggrave, des vaisseaux anormaux, les néovaisseaux, sont développés par l’œil pour amener plus d’oxygène et de nutriments. Ces néovaisseaux prolifèrent à des endroits où ils ne devraient pas et envahissent les structures internes de l’œil causant saignement, glaucome ou décollement de rétine. On parle alors de rétinopathie diabétique proliférative.
En plus de ces atteintes, le diabète cause classiquement une cataracte par augmentation du sucre ce qui représente une cause additionnelle de baisse de vision. La cornée, organe le plus innervé du corps humaine, est aussi touchée par la glycémie haute et les petits nerfs diminuent en concentration et en sensibilité pouvant induire une kératopathie neurotrophique, c’est-à-dire une baisse de la sensibilté cornéenne mettant à risque le patient d’infection et d’ulcère.
Enfin, le diabète peut aussi causer des parésies des muscles oculomoteurs.
Quand faire un dépistage et dois-je faire un contrôle annuel ?
Un suivi ophtalmologique régulier et assidu est donc requis pour tout patient diabétique. Si le patient ne présente aucune atteinte ophtalmologique, un suivi annuel est recommandé. En cas d’atteinte, le patient sera revu à intervalle régulier selon la gravité tenant compte des classifications.
En fonction de la gravité des lésions oculaires, votre médecin détermine, en plus de la surveillance, le traitement qui peut comprendre :
– le laser Argon rétinien
– les injections intravitréennes d’anti-VEGF / corticoïdes.
Votre ophtalmologue sera disposé à répondre à vos questions supplémentaires.